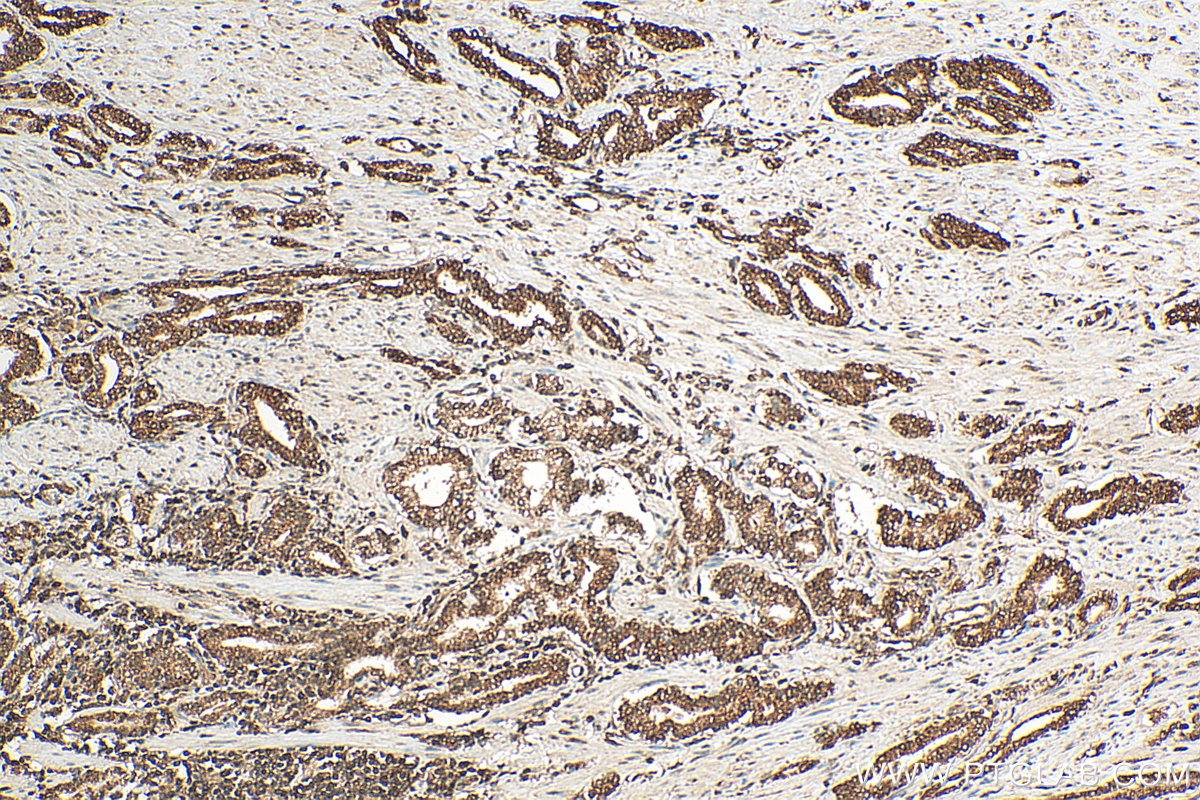

验证数据展示
经过测试的应用
| Positive WB detected in | HEK-293 cells, HeLa cells, mouse testis tissue, rat testis tissue |
| Positive IHC detected in | human lung cancer tissue, human prostate cancer tissue Note: suggested antigen retrieval with TE buffer pH 9.0; (*) Alternatively, antigen retrieval may be performed with citrate buffer pH 6.0 |
推荐稀释比
| 应用 | 推荐稀释比 |
|---|---|
| Western Blot (WB) | WB : 1:1000-1:4000 |
| Immunohistochemistry (IHC) | IHC : 1:50-1:500 |
| It is recommended that this reagent should be titrated in each testing system to obtain optimal results. | |
| Sample-dependent, Check data in validation data gallery. | |
产品信息
10070-1-AP targets UBC9 in WB, IHC, IP, ELISA applications and shows reactivity with human, mouse, rat samples.
| 经测试应用 | WB, IHC, ELISA Application Description |
| 文献引用应用 | WB, IP |
| 经测试反应性 | human, mouse, rat |
| 文献引用反应性 | human, mouse, zebrafish |
| 免疫原 |
CatNo: Ag0111 Product name: Recombinant human UBC9 protein Source: e coli.-derived, PGEX-4T Tag: GST Domain: 1-184 aa of BC004437 Sequence: VPGTLNMSGIALSRLAQERKAWRKDHPFGFVAVPTKNPDGTMNLMNWECAIPGKKGTPWEGGLFKLRMLFKDDYPSSPPKCKFEPPLFHPNVYPSGTVCLSILEEDKDWRPAITIKQILLGIQELLNEPNIQDPAQAEAYTIYWLVAALAPLVAAPPRPSQGRLAGREWSTQAHPRDSQGPRLC 种属同源性预测 |
| 宿主/亚型 | Rabbit / IgG |
| 抗体类别 | Polyclonal |
| 产品类型 | Antibody |
| 全称 | ubiquitin-conjugating enzyme E2I (UBC9 homolog, yeast) |
| 别名 | UBE2I, C358B7.1, E2,UBE2I, EC:2.3.2.-, P18 |
| 计算分子量 | 18 kDa |
| 观测分子量 | 18 kDa |
| GenBank蛋白编号 | BC051289 |
| 基因名称 | UBC9 |
| Gene ID (NCBI) | 7329 |
| RRID | AB_513699 |
| 偶联类型 | Unconjugated |
| 形式 | Liquid |
| 纯化方式 | Antigen affinity purification |
| UNIPROT ID | P63279 |
| 储存缓冲液 | PBS with 0.02% sodium azide and 50% glycerol, pH 7.3. |
| 储存条件 | Store at -20°C. Stable for one year after shipment. Aliquoting is unnecessary for -20oC storage. |
背景介绍
UBC9 is also named as UBE2I, UBCE9 and belongs to the ubiquitin-conjugating enzyme family. It is a homologue of the E2 ubiquitin conjugating enzyme and participates in the covalent linking of SUMO-1 molecule to the target protein. This protein is present at a high level in spleen and lung. Moderate level of UBC9 is detected in kidney and liver. Low amount of UBC9 is observed in brain, whereas the 18 kDa band of UBC9 is barely visible or absent in heart and skeletal muscle. In heart and muscle extracts the UBC9 antibodies recognizes a 38 kDa protein band,but this band is not visible in extracts of other rat tissues(PMID:14739995).
实验方案
| Product Specific Protocols | |
|---|---|
| IHC protocol for UBC9 antibody 10070-1-AP | Download protocol |
| WB protocol for UBC9 antibody 10070-1-AP | Download protocol |
| Standard Protocols | |
|---|---|
| Click here to view our Standard Protocols |
发表文章
| Species | Application | Title |
|---|---|---|
Chem Res Toxicol Natural Product Baohuoside I Impairs the Stability and Membrane Location of MRP2 Reciprocally Regulated by SUMOylation and Ubiquitination in Hepatocytes | ||
Biochem Biophys Res Commun Novel progerin-interactive partner proteins hnRNP E1, EGF, Mel 18, and UBC9 interact with lamin A/C. | ||
Biochem Biophys Res Commun SUMOylation of optineurin is critical for inhibiting interferon β production | ||
J Virol Multiple-Site SUMOylation of FMDV 3C Protease and Its Negative Role in Viral Replication | ||
Cancer Gene Ther METTL3-mediated RanGAP1 promotes colorectal cancer progression through the MAPK pathway by recruiting YTHDF1 | ||
Int J Biol Sci SUMO E3 ligase MUL1 inhibits lymph node metastasis of bladder cancer by mediating mitochondrial HSPA9 translocation |